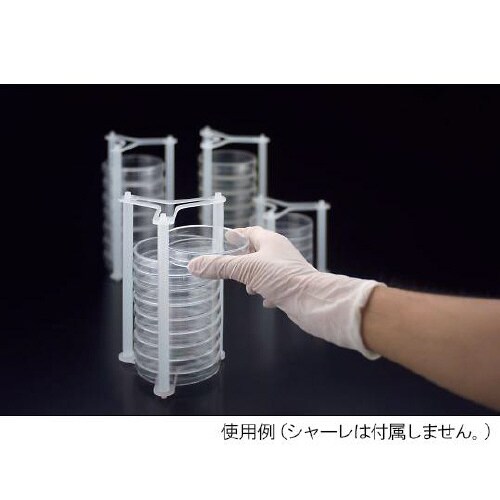
26941 ペトリマルチラック 10枚用

シャーレの売れ筋ランキング
- ¥564(税込) (税込) 〜
- ¥5,382(税込) (税込) 〜
- ¥12,435(税込) (税込) 〜
- ¥671(税込) (税込)
商品の特徴 |
側面からの出し入れが簡単ラックごとひっくり返せて安全保持積み重ねたシャーレをラックごと安定移動省スペース設計オートクレーブが可菌培養シャーレのラックにおススメ |
|---|---|
商品仕様 |
|
メーカー情報 |
|
カタログ掲載ページ |
-/- |
| 注意事項 | ※【返品に関するご注意】この商品は直送品のため、お客様のご都合による返品はお受けできません。 |
|---|